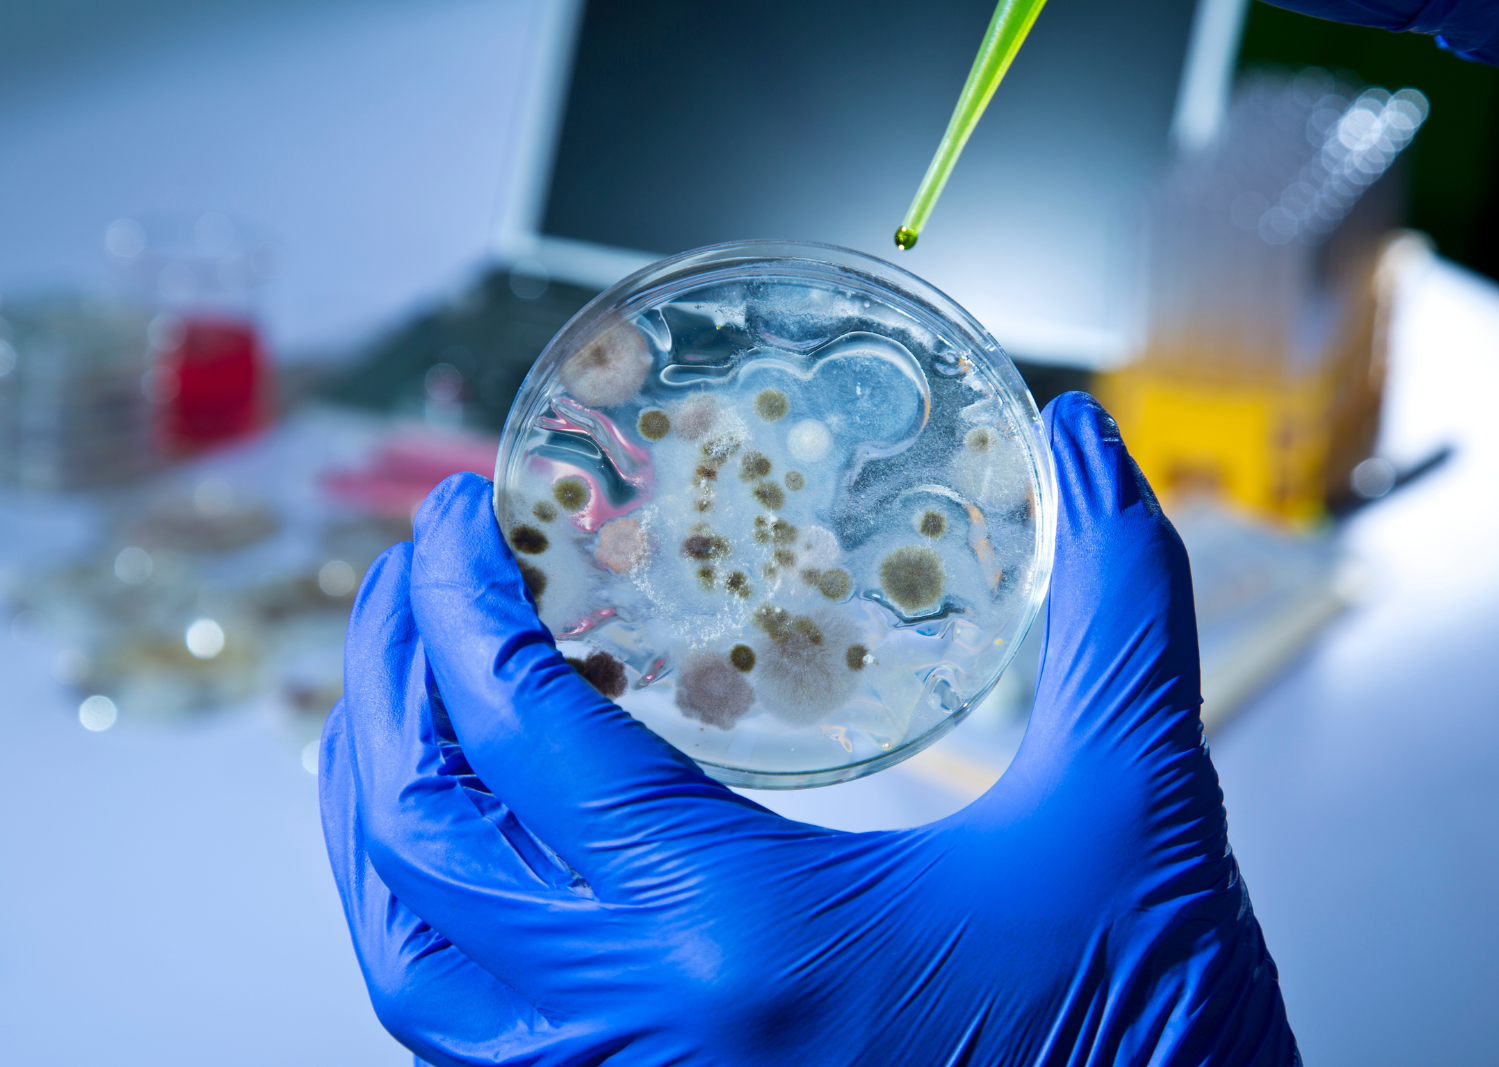

1
/
de
1
BVA Live 2024
Common faecal pathogens and their significance. Does every positive need to be treated?
Common faecal pathogens and their significance. Does every positive need to be treated?
Prix habituel
$20.00 USD
Prix habituel
Prix promotionnel
$20.00 USD
Quantité
Impossible de charger la disponibilité du service de retrait
This session will focus on common enteropathogens and faecal diagnostic techniques. We will focus on how to get the most out of faecal testing and how to avoid over interpretation and treatment with a particular focus on antibiotic stewardship.
- Know when to perform faecal testing
- Know how to interpret positive faecal results for common enteropathogens in dogs and cats
- Gain an understanding of how to diagnose and treat common enteropathogens in dogs and cats
Chairperson:
Delivered by:

Presented at BVA Live 2024
Referrals and Diagnostics Theatre
Thursday, 6 June, 15:45-16:30
Please note this session is not RACE-approved but you can still earn a CPD certificate
Share